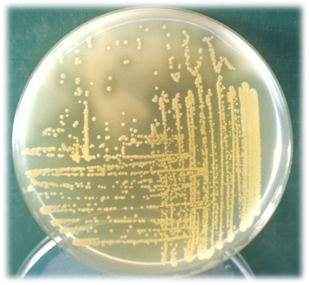
Staphylococcus aureus DNA-asa positivo (halo transparente tras unos minutos de añadir HCl en el cuadrante superior izquierdo)

Agar DNA-asa / Termonucleasa (UNE 34-820:1985)
Detección indirecta de la enterotoxina termoestable de Staphylococcus aureus
El Agar DNA-asa / Termonucleasa es un medio de cultivo diseñado para la detección indirecta de la enterotoxina termoestable (termonucleasa) producida por Staphylococcus aureus, siguiendo el método UNE 34-820:1985 (CENAN).
Este medio permite identificar estafilococos patógenos en función de su actividad DNA-ásica, un indicador clave de virulencia y capacidad enterotoxigénica.
⚗️ Composición del Agar DNA-asa / Termonucleasa
Por litro de medio:
- Triptosa: 20,0 g
- Ácido desoxirribonucleico: 2,0 g
- Cloruro sódico: 5,0 g
- Agar agar: 15,0 g
- pH final: 7,3 ± 0,2
En el caso de Staphylococcus aureus DNA-asa positivo, se observa un halo transparente tras unos minutos de añadir HCl, especialmente visible en el cuadrante superior izquierdo de la placa.
Preparación del medio
- Disolver 42 g de medio deshidratado en 1 litro de agua destilada.
- Calentar con agitación hasta ebullición.
- Autoclavar a 121 °C durante 15 minutos.
- Conservar el medio preparado entre 4 y 8 °C, en lugar fresco, seco y protegido de la luz.
- Agitar el frasco antes de usar.
Uso exclusivo en laboratorio. Mantener el envase bien cerrado para preservar sus propiedades.
Código deshidratado: DMT046
Control de calidad del medio
El control de calidad se realiza en los laboratorios MICROKIT, aunque se recomienda repetirlo en su propio laboratorio si:
- El medio lleva más de 3 meses sin usarse.
- Ha habido una desinfección general del laboratorio.
- Se ha almacenado a temperatura elevada.
- Presenta un aspecto anómalo aunque no haya caducado.
Staphylococcus aureus DNA-asa positivo (halo transparente
tras unos minutos de añadir HCl en el cuadrante superior izquierdo)
Características:
- Deshidratado: polvo fino de color beige.
- Preparado: estéril, color ámbar (azul si se añade azul de toluidina).
Prueba de fertilidad (18–48 h a 37 °C):
| Cepa de control | Resultado | Observación |
|---|---|---|
| Serratia marcescens MKTA 8412 | Excelente | Halo transparente tras añadir HCl |
| Staphylococcus aureus MKTA 6538P | Excelente | Halo transparente tras añadir HCl |
| Staphylococcus epidermidis MKTA 12228 | Excelente | Sin halo transparente |
Presentación disponible
- Tubos preparados con azul de toluidina.
- Frascos preparados (100 ml) con azul de toluidina.
- Medio deshidratado.
Principio del método y aplicación
El Agar Desoxirribonucleasa (DNA-asa) permite identificar estafilococos patógenos mediante la detección de la enzima DNA-asa, que degrada el ADN presente en el medio.
Se recomienda especialmente para confirmar la patogenicidad de colonias sospechosas de S. aureus aisladas en otros medios selectivos como Baird Parker, Mannitol Chapman o Vogel Johnson.
Aunque el calentamiento destruye las células de S. aureus, su enterotoxina puede resistir altas temperaturas, lo que puede originar toxiinfecciones alimentarias incluso tras procesos térmicos correctos.
Por ello, este método permite identificar indirectamente la presencia de enterotoxina estafilocócica termorresistente, correlacionada con la actividad termonucleasa.
Procedimiento para la detección de termonucleasa (método CENAN)
- Mezclar 1 g de muestra con 1 ml de agua destilada (30–40 °C).
- Triturar y homogeneizar.
- Ajustar el pH a 5,5.
- Calentar a 100 °C durante 20 minutos.
- Enfriar rápidamente en baño de hielo (4 °C).
- Centrifugar a 7.500 rpm durante 45 minutos.
- Empapar discos de celulosa (VAC158) con el sobrenadante.
- Colocarlos sobre una placa de Agar DNA-asa con azul de toluidina.
- Cubrir con otro tubo del mismo medio fundido (45 °C).
- Incubar 2–8 h a 50 °C.
➡️ La presencia de halos rosados alrededor de los discos indica actividad termonucleasa y, por tanto, la probable presencia de enterotoxina estafilocócica termorresistente.
Siembra e interpretación
- Fundir el medio preparado (frasco o tubo con azul de toluidina).
- Agitar para homogeneizar posibles fases oxidada/reducida.
- Sembrar por estría en superficie (placa o tubo inclinado) con la colonia sospechosa.
- Incubar 4–18 h a 37 °C.
- Añadir HCl 1 N (solo en el medio sin azul de toluidina).
Resultados:
- Colonias positivas: rodeadas de halo claro (lisis del ADN) o halo rosado (en el medio con azul de toluidina).
- Colonias negativas: sin halo de lisis.
♻️ El usuario es responsable de la eliminación segura de los microorganismos según la legislación medioambiental vigente.
Autoclavar antes de desechar.
Más información
Si desea más información sobre nuestro medio DNA-asa Test Agar, puede:
Rellenar el formulario de contacto en www.medioscultivo.com/contacto
Escribirnos a microkit@microkit.es
O llamarnos al 91 897 46 16
Más detalles técnicos disponibles en:
https://www.microkit.es/fichas/DNA-asa-TEST-AGAR.pdf

